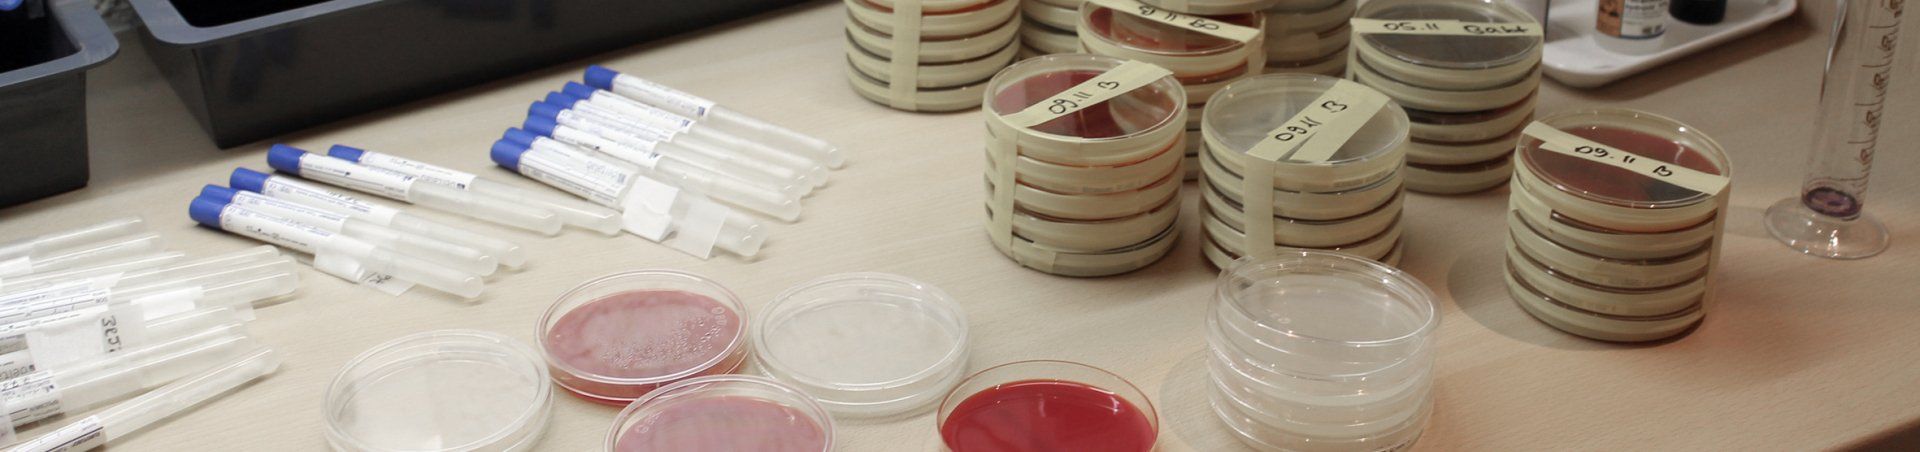

Labor
Im eigenen Labor erfolgt eine hochdifferenzierte Pilz- und Bakteriendiagnostik
mittels selektiver spezifischer Wachstumsmedien. Wir besitzen zur Untersuchung von Hautmaterial auf pathogene Pilze verschiedene Mikroskope, u.a. auch ein Fluoreszenzmikroskop, das einen besonders schnellen Nachweis von Pilzanteilen ermöglicht. Desweiteren erfolgt mit Hilfe der Gendiagnostik mittels
Polymerase-Ketten-Reaktion
ein hochspezifischer Erregernachweis. Daneben erfolgt in unserer Praxis eine Bestimmung der Bluteigenantikörper
(Gesamt IgE, spezifisches IgE) mit Hilfe hochtechnisierter RAST-Diagnosegeräte zur Allergendiagnostik.